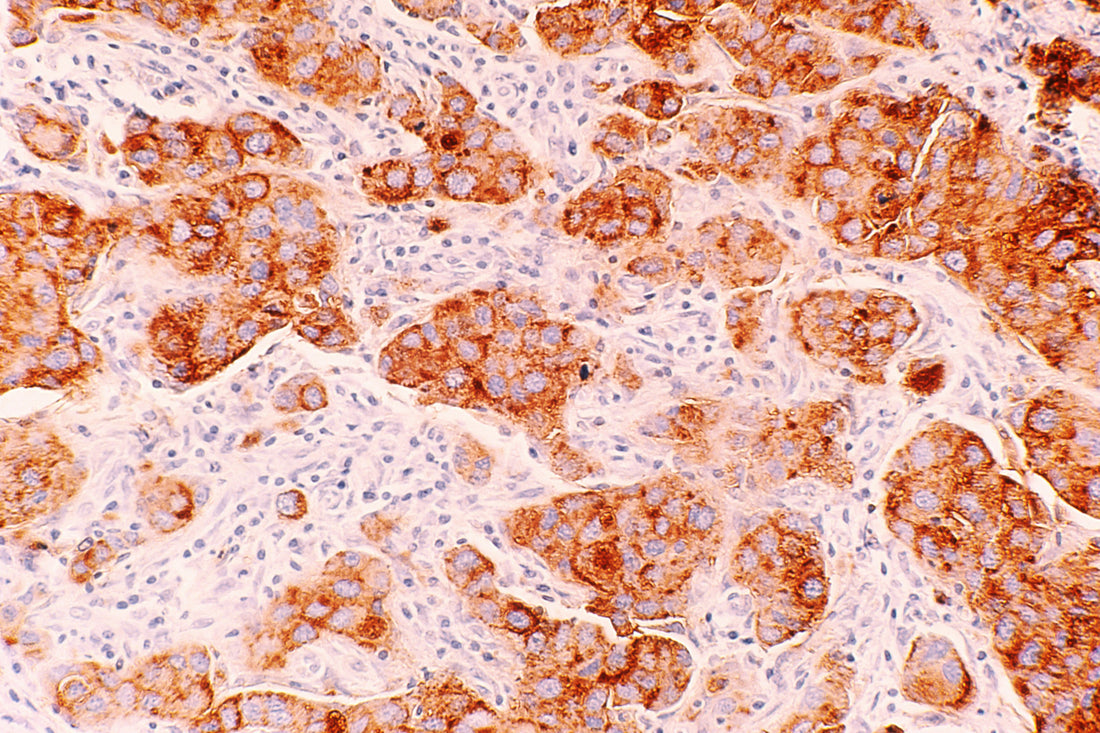

When it comes to understanding cancer and its vulnerabilities, the frequency range of 100,000 Hz to 300,000 Hz plays a crucial role. This specific range has been studied extensively by researchers and experts in the field of oncology.
What makes cancer vulnerable in this frequency range?
Studies have shown that cancer cells have a unique response to electromagnetic frequencies within the range of 100,000 Hz to 300,000 Hz. These frequencies have been found to disrupt the growth and proliferation of cancer cells, making them more susceptible to treatment.
How do these frequencies affect cancer cells?
Research has indicated that exposure to frequencies between 100,000 Hz and 300,000 Hz can induce apoptosis, or programmed cell death, in cancer cells. This process helps to eliminate cancer cells from the body and inhibit tumor growth.
What are the implications for cancer treatment?
The discovery of the vulnerability of cancer cells to frequencies within this range opens up new possibilities for cancer treatment. By targeting cancer cells with specific frequencies, researchers may be able to develop innovative therapies that are more effective and less invasive than traditional treatments.
Overall, the understanding of the vulnerability of cancer between 100,000 Hz and 300,000 Hz represents a significant advancement in the field of oncology. Further research and exploration of this frequency range could lead to groundbreaking developments in cancer treatment and improve outcomes for patients.
Photo by National Cancer Institute on Unsplash